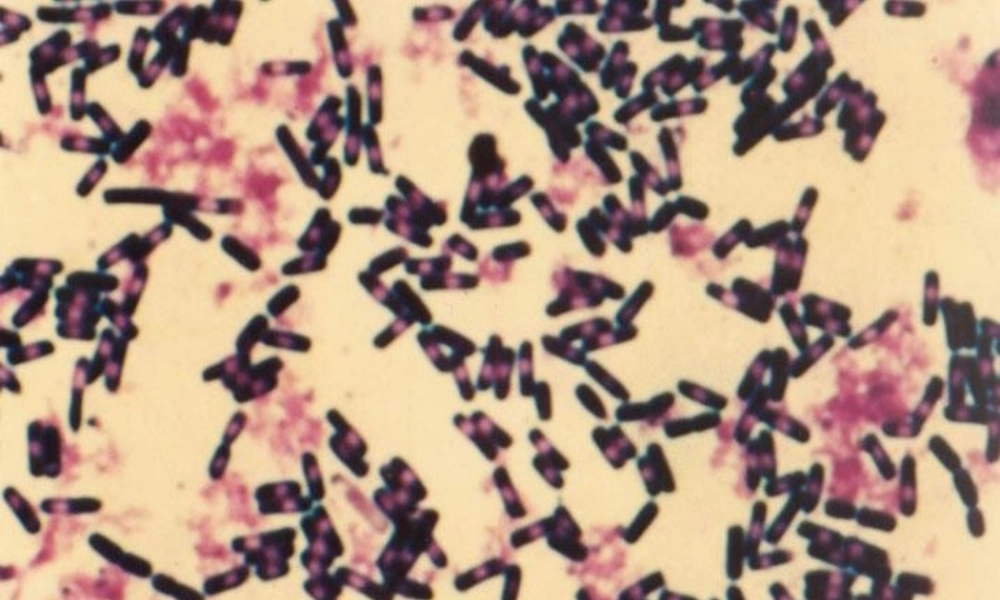
《细菌的启示》教学设计

细菌的启示郑也夫 郑也夫, 1950 年生,当代学者,现为中国人民大学社会学系教授,博士生导师
主要著作有《西方社会学史》、《走出囚徒困境》、《代价论》、《信任论》
本文是作者 2003 年 5 月 12 日“非典”期间在中国人民大学的一次精彩的演讲
· 认识作者· 整体感知要求:快速阅读课文,把握主要内容,划出重点字词
· 识记字词●名副其实 不卑不亢 砥砺 打喷嚏 奶酪 繁衍 笨拙●道高一尺 魔高一丈 束手待毙 不瘟不火 一以贯之 不可思议得天独厚读了本文,你觉得哪些地方改变了你对细菌的固有认识
或者哪些地方使你有所感悟
把这些地方划出来,说一说你的发现和感悟
· 学会感悟· 示例◆ 一粒普通的泥土中有几亿个细菌,人的一滴唾液中有几百万个细菌,甚至人体体重的 10% 是由细菌构成的
(细菌与我们的生活联系竟如此紧密
从数量上看,细菌不知要比人类强大多少倍,可以说,我们生活在细菌的包围之中
当然,这种包围对我们并没有多大伤害
)◆ 你看到天上有一只鸽子在飞,那哪是一只鸽啊,那是一个飞行的动物园
(一只鸽如此,一个人何尝不也是这样
我们的头发里有细菌,我们的衣服上有细菌,我们的肠胃里有细菌,看到一个人在走,就好像一个动物园在走——这是我们不能不承认的事实
)细菌的性质和特征细菌的性质和特征11 、细菌的历史最古老;、细菌的历史最古老;22 、细菌无所不在;、细菌无所不在;33 、细菌发挥着重要作用;、细菌发挥着重要作用;44 、细菌的不可毁灭性;、细菌的不可毁灭性;55 、细菌的生存策略多;、细菌的生存策略多;●我们走到最复杂的巅峰是偶然,只是偶然,连幸运都很难说
●复杂是它的幸运吗
进步一定能使物种长存吗
●尽管它看着不舒服,没有美感,没有尊严,恶心……你会觉得这种策略真是鬼聪明
· 学会思考本文有对常识的颠覆和批判,有对话性的交流和雄辩的表述,写出了作者的深